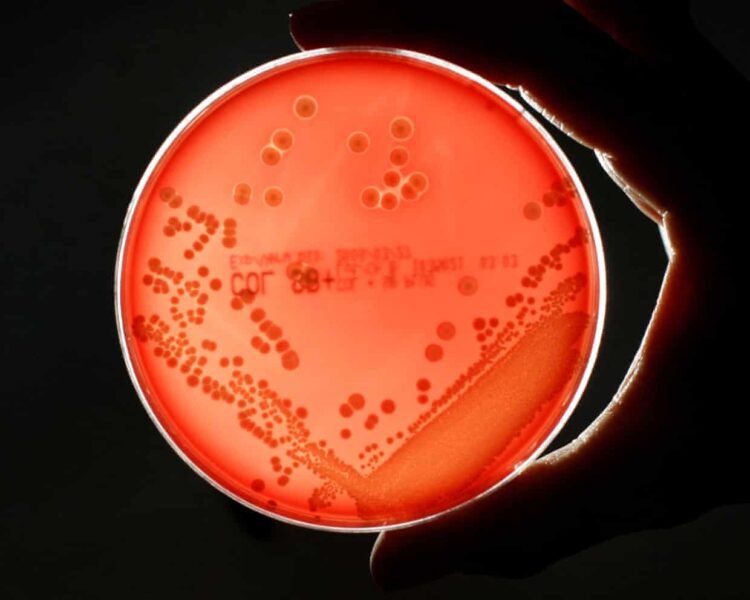

Dunia menghadapi ancaman serius dari resistensi antimikroba (AMR) atau bakteri super, yang diperkirakan dapat menyebabkan jutaan kematian dan kerugian ekonomi global mencapai USD 1,7 triliun (sekitar Rp34.000 triliun) per tahun pada 2050. Dilansir dari The Guardian, temuan ini berasal dari studi terbaru yang dilakukan Center for Global Development dan didanai oleh pemerintah Inggris.
Penelitian tersebut menyebut bahwa tanpa aksi global yang terkoordinasi, tingkat resistensi terhadap antibiotik akan terus meningkat. Negara-negara seperti Amerika Serikat, Inggris, dan kawasan Uni Eropa diprediksi akan menjadi yang paling terdampak dari sisi ekonomi dan kesehatan.
“Jika program pengendalian AMR terus mengalami pemotongan dana, kita akan menghadapi skenario terburuk. Ini bukan hanya krisis kesehatan, tapi juga bencana ekonomi,” kata Anthony McDonnell, penulis utama laporan itu.
Menurut proyeksi, resistensi antibiotik dapat menyebabkan kerugian produk domestik bruto (PDB) tahunan sebesar; USD 722 miliar di Tiongkok; USD 295,7 miliar di Tiongkok; USD 187 miliar di Uni Eropa; USD 65,7 miliar di Jepang dan USD 58,6 miliar di Inggris.
Tak hanya itu, jumlah kematian akibat infeksi yang kebal obat diperkirakan melonjak 60% pada 2050, mencapai 1,34 juta kasus di AS dan 184.000 kasus di Inggris per tahun. Peningkatan ini juga akan menyebabkan biaya pengobatan melonjak signifikan karena infeksi bakteri yang resisten membutuhkan perawatan lebih lama dan lebih kompleks.
Misalnya, biaya kesehatan akibat AMR diproyeksikan meningkat menjadi USD 176 miliar per tahun secara global, termasuk lonjakan biaya di Inggris dari USD 900 juta menjadi USD 3,7 miliar dan di AS dari USD 15,5 miliar menjadi USD 57 miliar.
Penurunan produktivitas juga menjadi perhatian. Studi tersebut memperkirakan tenaga kerja akan berkurang hingga: 0,8% di Inggris, 0,6% di Uni Eropa dan 0,4% di AS.
Ironisnya, studi ini dipublikasikan di tengah gelombang pemotongan besar-besaran anggaran bantuan luar negeri. Pemerintah Inggris baru saja menghentikan pendanaan untuk Dana Fleming—program yang mendukung negara berkembang dalam memerangi AMR. Sementara itu, pemerintahan Trump juga memangkas anggaran bantuan luar negeri hingga USD 9 miliar.
Pemotongan tersebut dikhawatirkan memperburuk penyebaran bakteri super di negara-negara berpenghasilan rendah dan menengah, yang akhirnya berdampak secara global, termasuk ke negara-negara G7.
“Negara-negara maju pun tidak kebal terhadap ancaman ini. Infeksi yang tadinya bisa disembuhkan bisa berubah menjadi mematikan jika obat-obatan kita tidak lagi bekerja,” ujar Dr. Mohsen Naghavi dari Institute for Health Metrics and Evaluation (IHME).
Namun, studi ini juga menegaskan bahwa investasi dalam pengembangan antibiotik baru dan peningkatan akses terhadap pengobatan berkualitas dapat membalikkan situasi. Jika dilakukan secara serius, ekonomi AS diproyeksikan akan tumbuh tambahan USD 156,2 miliar per tahun, sementara Inggris bisa memperoleh keuntungan hingga USD 12 miliar per tahun pada 2050.
Pemerintah Inggris sendiri mengklaim telah menyusun rencana kesehatan nasional jangka panjang yang mengakui AMR sebagai salah satu ancaman utama. “Kami telah membuat kemajuan signifikan, termasuk mengurangi penggunaan antibiotik di sektor peternakan dan menerapkan model insentif bagi pengembangan obat baru. Upaya ini kami jalankan bersama mitra internasional,” ujar juru bicara pemerintah Inggris.***